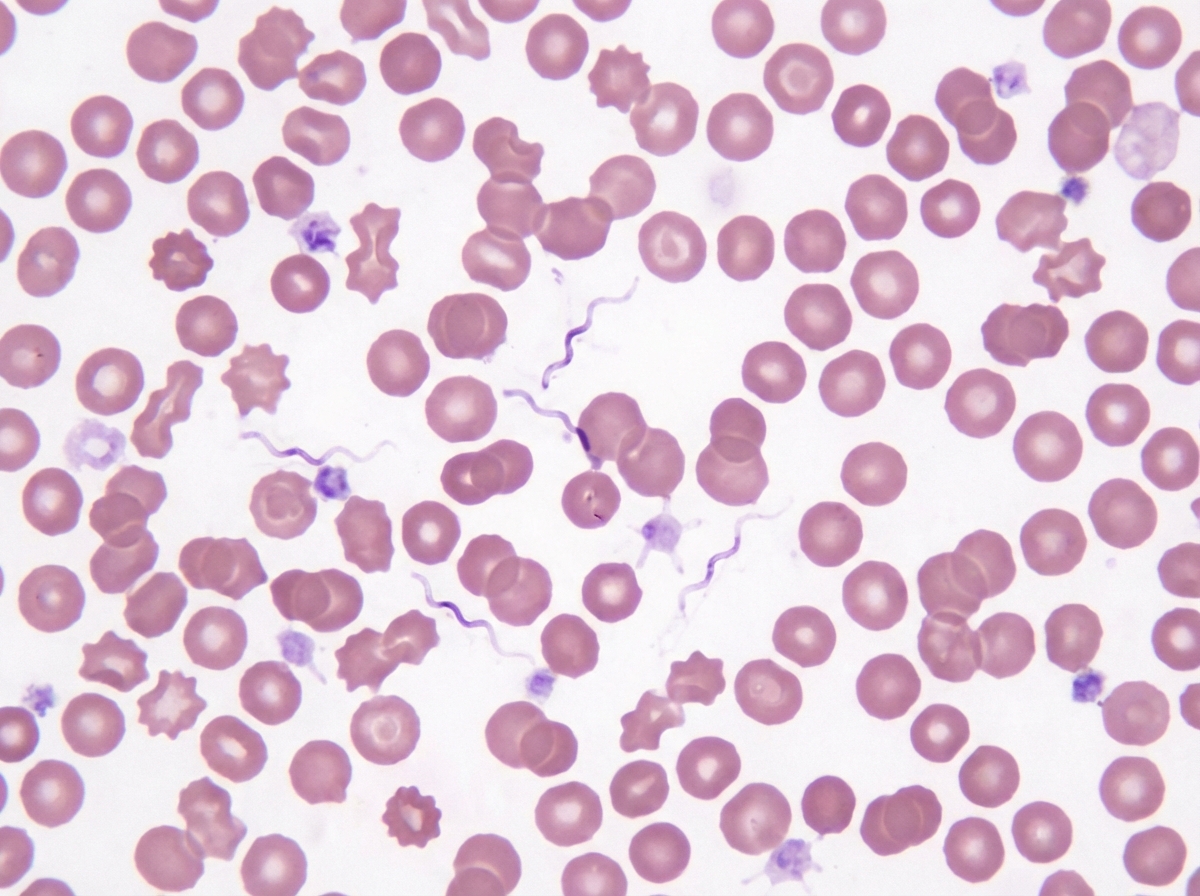
Image for question 1320

Which of the following statements regarding gullwing-shaped bacteria is FALSE?
Staphylococcus aureus produces a superantigen that contributes to massive cytokine release and polyclonal T-cell activation. Which of the following best fits this description of a superantigen?
Buffered charcoal yeast extract agar is a selective medium for which bacterium?
Inspissation is used for?
All of the following statements regarding Clostridium tetani are true, except?
Which of the following statements about Gram-positive cocci is false?
Which of the following statements regarding L-forms of bacteria is FALSE?
All of the following bacteria show bipolar staining except?
Coagulase-negative staphylococci includes all of the following except?
Peripheral blood smear of a patient with relapse of a fever seven days after remittance is shown. What is a true statement about the etiological agent?
Explanation: The question refers to **Campylobacter jejuni**, which is classically described as having a **"gull-wing"** or "comma" shape (Gram-negative, curved bacilli). ### **Why Option B is the Correct (False) Statement** While *Campylobacter jejuni* is indeed **microaerophilic** (requiring 5–10% oxygen), its optimal growth temperature is **42°C**, not 37°C. This thermophilic nature is a key diagnostic feature used to isolate it from other enteric pathogens in stool samples using selective media like Skirrow’s or Campy-BAP. ### **Analysis of Other Options** * **Option A:** Poultry (especially undercooked chicken) is the most common source of infection. It is a zoonotic pathogen. * **Option C:** It causes **inflammatory diarrhea** (dysentery) characterized by blood and pus in stools due to mucosal invasion and toxin production. * **Option D:** *C. jejuni* is the most common antecedent infection associated with **Guillain-Barré Syndrome (GBS)**. This occurs via **molecular mimicry**, where antibodies against the bacterial lipooligosaccharides (LOS) cross-react with gangliosides in human peripheral nerves. ### **High-Yield Clinical Pearls for NEET-PG** * **Morphology:** Described as "Gull-wing," "S-shaped," or "Spiral." * **Motility:** Shows characteristic **"Darting motility"** on hanging drop preparation. * **Culture:** Requires selective media (e.g., **Preston medium**, **Skirrow’s medium**) and incubation at **42°C**. * **Complications:** Apart from GBS, it is also associated with **Reactive Arthritis** (Reiter’s Syndrome). * **Drug of Choice:** Macrolides (e.g., Azithromycin) are preferred if treatment is indicated.
Explanation: ### Explanation **1. Why the Correct Answer is Right:** **Toxic Shock Syndrome Toxin-1 (TSST-1)** is the classic example of a **superantigen**. Unlike conventional antigens that are processed and presented in the MHC II groove, superantigens bind directly to the **external surface** of the **MHC class II** molecule on Antigen Presenting Cells (APCs) and the **Vβ region of the T-cell receptor (TCR)**. This bypasses the specificity of the immune response, leading to the non-specific, **polyclonal activation** of up to 20% of the body's T-cells. This results in a "cytokine storm" (massive release of IL-1, IL-2, TNF-α, and IFN-γ), causing the clinical triad of high fever, hypotension, and a diffuse erythematous rash. **2. Why the Other Options are Incorrect:** * **A. Exfoliative Toxin:** This is a serine protease that targets **desmoglein-1** in the stratum granulosum. It causes Staphylococcal Scalded Skin Syndrome (SSSS) but does not act as a systemic superantigen. * **B. Protein A:** This is a surface component that binds to the **Fc portion of IgG**, preventing opsonization and phagocytosis. It is an antiphagocytic virulence factor, not a superantigen. * **C. Coagulase:** An enzyme that converts fibrinogen to fibrin to coat the bacteria and evade the immune system. It is used as a diagnostic marker for *S. aureus* but does not trigger cytokine release. **3. High-Yield Clinical Pearls for NEET-PG:** * **Mechanism:** Superantigens cross-link MHC II and Vβ-TCR. * **Other Superantigens:** Staphylococcal enterotoxins (food poisoning) and Streptococcal Pyrogenic Exotoxin (SpeA/C). * **Clinical Link:** TSST-1 is historically associated with highly absorbent tampon use, but can also occur in post-operative wound infections. * **Diagnostic Key:** TSST-1 causes multisystem failure; look for "sunburn-like rash" followed by desquamation (palms and soles).
Explanation: **Explanation:** **Legionella pneumophila** is the correct answer because it is a fastidious, Gram-negative rod that requires specific growth factors not found in standard media. **Buffered Charcoal Yeast Extract (BCYE) agar** is the specialized selective medium designed for its isolation. * **The Science of BCYE:** Legionella requires **L-cysteine** and **iron** (ferric pyrophosphate) for growth. The yeast extract provides the protein base, while the **activated charcoal** serves a critical role: it neutralizes toxic peroxides and metabolic byproducts produced by the bacteria during growth, which would otherwise inhibit its multiplication. **Analysis of Incorrect Options:** * **Listeria monocytogenes:** Typically grown on blood agar or selective media like PALCAM/Oxford agar. It is known for its "tumbling motility" and ability to grow at 4°C (cold enrichment). * **Pseudomonas aeruginosa:** A non-fastidious aerobe that grows easily on MacConkey agar (as non-lactose fermenters) and produces characteristic pigments (pyocyanin/pyoverdin) on Cetrimide agar. * **Treponema pallidum:** This is an obligate spirochete that **cannot be cultured** on artificial media. It is identified via dark-field microscopy or serology (VDRL/RPR). **High-Yield Clinical Pearls for NEET-PG:** * **Stain:** Legionella stains poorly with Gram stain; **Silver (Dieterle) stain** is preferred. * **Clinical Presentation:** Causes **Legionnaires' disease** (severe pneumonia with diarrhea and hyponatremia) and **Pontiac fever** (mild flu-like illness). * **Source:** Often associated with contaminated water systems, air conditioners, and cooling towers. * **Diagnosis:** The **Urinary Antigen Test** is the rapid test of choice in clinical settings.
Explanation: **Explanation:** **Inspissation** is a specialized sterilization technique used for culture media containing high amounts of heat-labile proteins, such as serum or egg. The underlying principle is that these proteins coagulate when heated, forming a solid medium. 1. **Why Option B is correct:** Inspissation involves heating the medium at **80-85°C for 30 minutes on three successive days**. This temperature is sufficient to solidify (inspissate) the protein without denaturing it to the point of losing its nutritional properties. Classic examples include **Lowenstein-Jensen (LJ) medium** (contains egg) and **Loeffler’s Serum Slope** (contains serum). 2. **Why other options are incorrect:** * **Option A (Sputum):** Sputum is a clinical specimen, not a medium. It is usually decontaminated (e.g., using NALC-NaOH) rather than inspissated. * **Option C (Serum containing medium):** While serum media *are* inspissated, "Protein containing culture medium" is the more comprehensive and standard answer as it encompasses both egg and serum-based media. (Note: In some contexts, both B and C are technically correct, but B is the broader category). * **Option D (Plasma sterilization):** Plasma sterilization (Hydrogen Peroxide Gas Plasma) is a low-temperature method used for heat-sensitive medical devices (e.g., endoscopes), not for culture media preparation. **High-Yield Clinical Pearls for NEET-PG:** * **LJ Medium:** Used for *Mycobacterium tuberculosis*. * **Loeffler’s Serum Slope:** Used for *Corynebacterium diphtheriae*. * **Fractional Sterilization:** Inspissation is a form of fractional sterilization (similar to Tyndallization) because it uses repeated heating to kill vegetative forms and allow spores to germinate and be killed on subsequent days. * **Temperature Check:** Remember, Inspissation = **80-85°C**, whereas Tyndallization = **100°C**.
Explanation: **Explanation** The correct answer is **A. Spores are resistant to heat.** While *Clostridium tetani* spores are indeed highly resistant to environmental conditions, they are **not** resistant to all forms of heat. They are killed by autoclaving at 121°C for 20 minutes. In the context of this question, the statement is considered "false" because the spores are susceptible to standard sterilization techniques, unlike some other highly resistant pathogens. **Analysis of other options:** * **B. Primary immunization consists of three doses:** This is a true statement. According to the National Immunization Schedule, primary vaccination for tetanus (as part of Pentavalent/DPT) is given at 6, 10, and 14 weeks. * **C. Incubation period is 6-10 days:** This is true. While the range can be 3 to 21 days, the average incubation period is approximately 7–10 days. A shorter incubation period is clinically associated with a worse prognosis. * **D. Person to person transmission does not occur:** This is true. Tetanus is an infectious disease but not a contagious one. It is acquired through environmental exposure (soil/dust) via contaminated wounds; it does not spread from one human to another. **High-Yield Clinical Pearls for NEET-PG:** * **Morphology:** Characterized by "Drumstick appearance" due to terminal, spherical spores. * **Pathogenesis:** Mediated by **Tetanospasmin**, a potent neurotoxin that blocks the release of inhibitory neurotransmitters (GABA and Glycine) from Renshaw cells in the spinal cord. * **Clinical Signs:** Trismus (lockjaw), Risus sardonicus (grimace), and Opisthotonus (archback) posture. * **Management:** Treatment involves wound debridement, Metronidazole (preferred over Penicillin), and Tetanus Immunoglobulin (TIG).
Explanation: ### Explanation The correct answer is **C**. While many clinicians associate Enterococci with high levels of antibiotic resistance, the statement is technically false in a microbiological context because **most *Enterococcus faecalis* (the most common species) remain susceptible to Penicillin/Ampicillin.** Resistance is more frequently seen in *Enterococcus faecium*. Enterococci are "intrinsically resistant" to cephalosporins and aminoglycosides (monotherapy), but penicillin remains a backbone of treatment unless high-level resistance is specifically detected. **Analysis of Other Options:** * **Option A:** *Staphylococcus saprophyticus* is a common cause of "honeymoon cystitis" (UTIs) in young, sexually active females. It is characteristically **Novobiocin resistant**. * **Option B:** Micrococci are often confused with Staphylococci. A key biochemical differentiator is that **Micrococci are oxidase-positive**, while Staphylococci are oxidase-negative. * **Option C:** *Streptococcus pneumoniae* (Pneumococcus) is a classic **encapsulated** organism. Its polysaccharide capsule is the primary virulence factor and the basis for the Quellung reaction and current vaccines. **NEET-PG High-Yield Pearls:** * **Enterococci:** Exhibit "Double Zone of Hemolysis" on blood agar and can grow in **6.5% NaCl** and **40% bile**. * **Treatment:** For serious Enterococcal infections (like endocarditis), a combination of Cell Wall Synthesis Inhibitors (Penicillin/Vancomycin) + Aminoglycosides is used for **synergistic bactericidal activity**. * **Catalase Test:** Used to differentiate Staphylococci (+) from Streptococci (-). * **Bile Solubility:** Pneumococci are bile soluble, whereas Viridans streptococci are not.
Explanation: ### Explanation **1. Why Option C is the Correct Answer (The False Statement):** L-forms (cell wall-deficient bacteria) can develop from **both Gram-positive and Gram-negative bacteria**. They are produced when bacteria are subjected to environmental stress or cell wall-active agents (like Penicillin or Lysozymes) that interfere with peptidoglycan synthesis. Since both Gram-positive and Gram-negative bacteria possess peptidoglycan, both can transition into L-forms. **2. Analysis of Other Options:** * **Option A (True):** L-forms are defined as strains of bacteria that lack a conventional cell wall but are capable of growth and division. Unlike protoplasts or spheroplasts, L-forms can replicate on specialized media. * **Option B (True):** L-forms were first discovered by **Emmy Klieneberger-Nobel** in 1935 at the Lister Institute (hence the name "L" form). They were first isolated from the bacterium ***Streptobacillus moniliformis***. * **Option D (True):** Because L-forms lack a cell wall, they are **intrinsically resistant** to beta-lactam antibiotics (which target the cell wall). This allows the bacteria to survive in a "dormant" or "stealth" state during treatment, potentially leading to chronic or recurrent infections once the antibiotic pressure is removed. **3. NEET-PG High-Yield Clinical Pearls:** * **Protoplast vs. Spheroplast:** Protoplasts are derived from Gram-positives (complete wall loss); Spheroplasts are derived from Gram-negatives (partial wall loss). * **Mycoplasma vs. L-forms:** Mycoplasma *naturally* lacks a cell wall and contains sterols in the membrane. L-forms are *induced* variants of bacteria that normally have walls and usually do not contain sterols. * **Culture:** L-forms require **hypertonic media** to prevent osmotic lysis and typically produce "fried-egg" colonies, similar to Mycoplasma.
Explanation: **Explanation:** Bipolar staining, often described as a **"safety-pin appearance,"** is a characteristic feature of certain Gram-negative bacteria where the ends of the bacilli stain more intensely than the center. This occurs due to the accumulation of storage granules or specific capsular material at the poles. **Why Haemophilus influenzae is the correct answer:** * **Haemophilus influenzae** is a small, pleomorphic, Gram-negative coccobacillus. While it can appear in various shapes, it **does not** exhibit bipolar staining. It typically stains uniformly with Safranin or basic fuchsin. **Analysis of Incorrect Options (Bacteria that DO show bipolar staining):** * **Yersinia pestis:** The classic example of bipolar staining (best seen with Wayson, Giemsa, or Methylene blue stains). It is the causative agent of Plague. * **Francisella tularensis:** A tiny, pleomorphic coccobacillus that causes Tularemia; it frequently demonstrates bipolarity. * **Pasteurella multocida:** Commonly associated with animal bites (cats/dogs), this organism characteristically shows bipolar staining, especially in tissue samples. **NEET-PG High-Yield Pearls:** 1. **Mnemonic for Bipolar Staining:** Remember **"Y.P.F.B."** (Your Pets Feel Better) or **"Way to Go"** for **W**hitmore’s bacillus (*Burkholderia pseudomallei*), **Y**ersinia, **P**asteurella, and **F**rancisella. 2. **Burkholderia pseudomallei:** Also shows a prominent safety-pin appearance and causes Melioidosis. 3. **Vibrio cholerae:** Occasionally shows bipolar staining, though its "comma shape" is more diagnostic. 4. **Stains used:** While Gram stain can show it, **Wayson stain** or **Leishman/Giemsa stains** are superior for demonstrating the safety-pin morphology.
Explanation: ### Explanation The primary biochemical test used to differentiate species within the genus *Staphylococcus* is the **Coagulase test**. This test detects the enzyme coagulase, which converts fibrinogen to fibrin. **1. Why Staph intermedius is the correct answer:** While the majority of staphylococci are Coagulase-Negative (CoNS), a few species other than *S. aureus* are **Coagulase-Positive**. *Staphylococcus intermedius* is a significant veterinary pathogen (commonly found in dogs) that tests positive for coagulase. Therefore, it does not belong to the CoNS group. Other coagulase-positive species include *S. hyicus* and *S. schleiferi* subsp. *coagulans*. **2. Analysis of Incorrect Options (CoNS members):** * **S. epidermidis:** The most common CoNS. It is a normal skin commensal but a leading cause of prosthetic valve endocarditis and infections related to indwelling medical devices (due to biofilm production). It is **Novobiocin sensitive**. * **S. saprophyticus:** A common cause of urinary tract infections (UTI) in young, sexually active females ("Honey-moon cystitis"). It is characteristically **Novobiocin resistant**. * **S. haemolyticus:** The second most frequently isolated CoNS; known for causing opportunistic infections and showing increasing resistance to vancomycin. **Clinical Pearls for NEET-PG:** * **Novobiocin Test:** Used to differentiate CoNS. *S. saprophyticus* is Resistant, while *S. epidermidis* is Sensitive. * **Biofilm (Slime layer):** The key virulence factor for *S. epidermidis*, allowing it to adhere to catheters and prosthetic joints. * **Urease Test:** *S. saprophyticus* is urease-positive, which contributes to its pathogenesis in the urinary tract.
Explanation: ***A soft tick or body louse can transmit the disease.*** - **Borrelia** species causing relapsing fever are transmitted by **soft ticks** (Ornithodoros species) or **body lice** (Pediculus humanus corporis). - The **spirochetes** visible in peripheral blood smear during febrile episodes are characteristic of **tick-borne** or **louse-borne relapsing fever**. *The only reservoir is humans.* - Most **Borrelia** species have **rodents and small mammals** as primary reservoirs, not exclusively humans. - Only **B. recurrentis** (louse-borne) has humans as the sole reservoir, but tick-borne species have animal reservoirs. *The vector is a hard tick or body louse.* - **Hard ticks** (Ixodes) transmit **Lyme disease** caused by B. burgdorferi, not relapsing fever. - Relapsing fever is specifically transmitted by **soft ticks** (Ornithodoros) or body lice, not hard ticks. *It is non-cultivable on cell-free media.* - **Borrelia** species can be cultured on specialized media like **Barbour-Stoenner-Kelly (BSK) medium**. - Unlike some obligate intracellular pathogens, Borrelia can grow in **cell-free artificial media** under specific conditions.
Staphylococci
Practice Questions
Streptococci and Enterococci
Practice Questions
Neisseria and Moraxella
Practice Questions
Corynebacterium and Listeria
Practice Questions
Bacillus and Clostridium
Practice Questions
Enterobacteriaceae
Practice Questions
Vibrio, Aeromonas, and Plesiomonas
Practice Questions
Pseudomonas and Related Bacteria
Practice Questions
Haemophilus and HACEK Group
Practice Questions
Bordetella and Brucella
Practice Questions
Mycobacteria
Practice Questions
Spirochetes
Practice Questions
Get full access to all questions, explanations, and performance tracking.
Start For Free